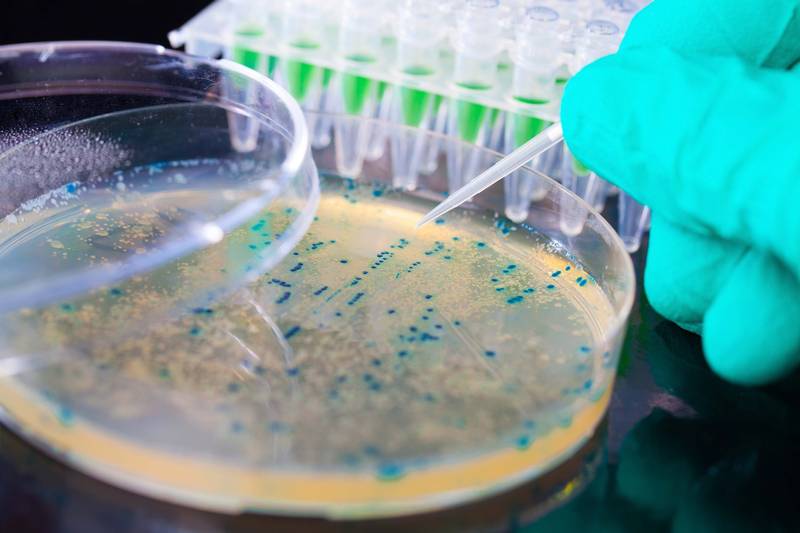

•Le PPPE est un projet
encadré par une équipe pédagogique dont l’acteur principal reste l’étudiant. Ce
dernier se place dans une démarche qui lui permet, au cours de sa formation, de
construire son avenir professionnel en prenant en considération son évolution
personnelle, sans déterminisme. Le présent cours vise à apprendre comment rédiger un rapport de stage afin de l'utiliser comme support d'aide au cours du stage des étudiants de la Licence Professionnelle COFFEE.
Pour accéder au cours, copier le lien html ci-dessous et le coller dans un nouvel onglet:- Enseignant: YASSINE GUEROUI
Cette matière a pour objectif d’expliquer l’élaboration d’un protocole évaluant l’innocuité des substances pouvant entrer dans les aliments, mais également l’approche biochimique des diverses phases des relations toxique-organisme. Il vise donc l’explication des mécanismes de la toxicité.
Ainsi face à un régime alimentaire présentant un déséquilibre ou une adjonction des substances xénobiotiques, expliquer le double aspect des relations toxique-organisme en introduisant les notions de phases toxico-cinétiques et toxico-dynamiques de l’effet toxique.
- Enseignant: FATMA DJAMAA